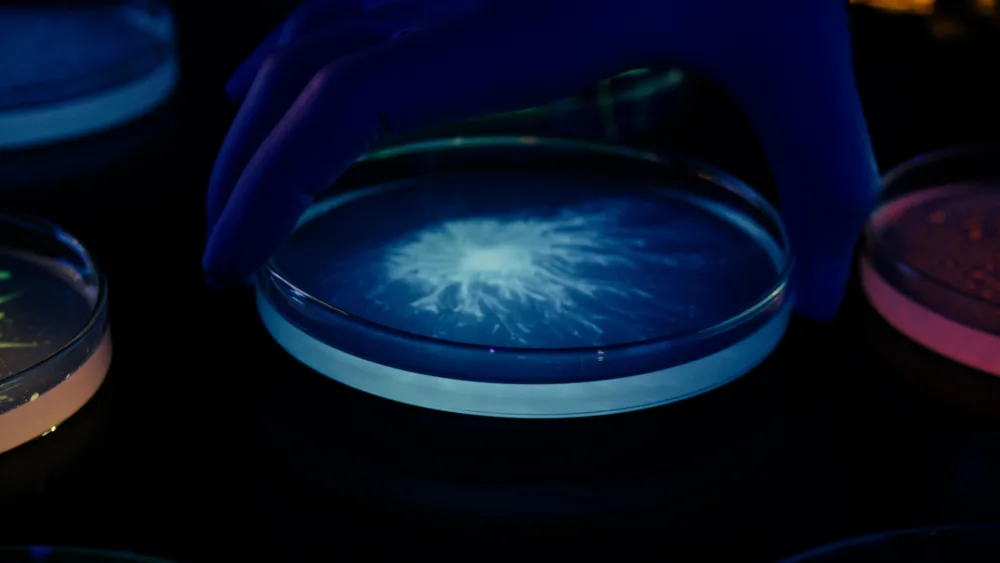
​L'ORÉAL: Αποκτά την ερευνητική εταιρεία Lactobio

L'ORÉAL: Αποκτά την ερευνητική εταιρεία Lactobio
18/12/2023 | 14:25
08/08/2025 | 21:38
Ενισχύει την ηγετική της θέση στην έρευνα μικροβιώματος για να ανοίξει νέους δρόμους στην καινοτομία των καλλυντικών
Η L'Oréal ανακοίνωσε σήμερα ότι ολοκλήρωσε την εξαγορά της Lactobio, κορυφαίας εταιρείας στην έρευνα προβιοτικών και μικροβιωμάτων με έδρα την Κοπεγχάγη.
Η στρατηγική εξαγορά έθεσε τα θεμέλια της στα 20 χρόνια προηγμένης έρευνας της L'Oréal στον επιστημονικό τομέα του μικροβιώματος, εμβαθύνοντας τις γνώσεις της για τους μικροοργανισμούς που ζουν στην επιφάνεια του δέρματος και ενισχύοντας την ηγετική θέση του Ομίλου σε αυτόν τον τομέα. Η εξαγορά ανοίγει επίσης νέες επιστημονικές ευκαιρίες, συμπεριλαμβανομένης της αξιοποίησης της τεχνογνωσίας της Lactobio στο μικροβίωμα και του σημαντικού χαρτοφυλακίου της IP για την ανάπτυξη ασφαλών και αποτελεσματικών λύσεων στο χώρο των καλλυντικών, χρησιμοποιώντας ζωντανά βακτήρια.
Η Lactobio ιδρύθηκε το 2017 από τους Δρ. Søren Kjærulff και Charlotte Vedel, οι οποίοι ανέπτυξαν μια μοναδική, αποκλειστική πλατφόρμα ανακάλυψης μικροβιώματος και μέθοδο ελέγχου για την επιλογή των πιο αποτελεσματικών και ασφαλών στελεχών. Αυτά τα προβιοτικά ακριβείας, που δημιουργήθηκαν από μια μεγάλη βιοτράπεζα βακτηρίων γαλακτοβάκιλλων, θα χρησιμοποιηθούν στην ανάπτυξη τοπικών σκευασμάτων που περιέχουν ζωντανά βακτήρια, εμπνευσμένα από τη φύση και με στόχο να προσδώσουν πολλαπλά οφέλη στο δέρμα και τα μαλλιά.
«Η ενσωμάτωση της Lactobio στον τομέα Advanced Research της L'Oréal είναι άκρως συμπληρωματική: η ισχυρή επιστημονική γνώση και η τεχνολογική πρόοδος της L'Oréal σε συνδυασμό με τις καλύτερες συνθέσεις της Lactobio στην κατηγορία που χρησιμοποιούν ζωντανούς οργανισμούς, θα ενισχύσουν και θα επιταχύνουν σημαντικά την έρευνα μικροβιώματος που εστιάζει στην ομορφιά», δήλωσε η Anne Colonna , Global Head of Advanced Research του Ομίλου L'Oréal. «Ενώνοντας τις δυνάμεις μας, στοχεύουμε να αναπτύξουμε μια νέα γενιά καλλυντικών που θα χρησιμοποιεί κορυφαίες καινοτομίες στη διαδικασία σύνθεσης για να παρέχει επιστημονικά, προβιοτικά και μεταβιοτικά προϊόντα ακριβείας με νέα επίπεδα απόδοσης».
«Η Δανία έχει μακρά ιστορία καινοτομίας που βασίζεται σε ζωντανούς μικροοργανισμούς που εφαρμόζονται στα τρόφιμα, τη γεωργία και την υγεία, και σε αυτό το πλαίσιο εμπνευστήκαμε να δημιουργήσουμε τη Lactobio», δήλωσε ο Søren Kjærulff, ιδρυτής και επικεφαλής επιστημονικός υπεύθυνος της Lactobio. «Είμαι ιδιαίτερα περήφανος για όσα έχει επιτύχει η ομάδα μας και ενθουσιασμένος για το μέλλον μας, ως μέρος του Ομίλου L'Oréal , καθώς μαζί, μπορούμε να εφαρμόσουμε την έρευνα μικροβιώματος σε νέα πεδία καινοτομίας στο χώρο της ομορφιάς για ανθρώπους σε όλο τον κόσμο».
Σχολιάστε